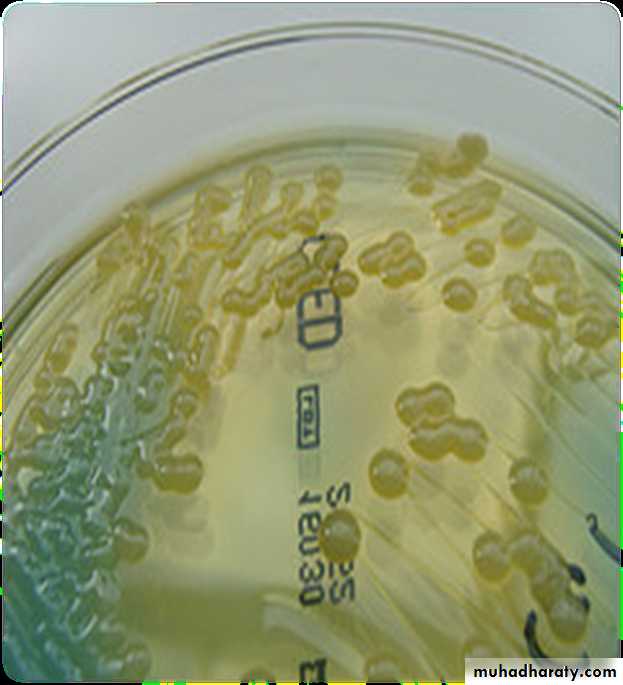

Actinomycetes,
Actinomycetes, which were formerly thought to be fungi, are true bacteria with long, branching flaments analogous to fungal hyphae.The two important genera of this group areActinomyces and Nocardia.
The chemical structure of the cell wall of these organisms is similar to that of corynebacteriaand mycobacteria, and some are acid-fast.Actinomyces spp. are microaerophilic or anaerobic; Nocardia spp. are aerobic organisms
CytoplasmLipoteichoic acid
Peptidoglycan-teichoic acidCytoplasmic membrane
GRAM POSITIVE CELL ENVELOPE
Degradative enzymeActinomyces spp
Although most Actinomyces are soil organisms, the potentially pathogenic species are commensals of the mouth in humans and animals.
They are a major component of dental plaque, particularly at approximal sites of teeth, and areknown to increase in numbers in gingivitis.
An association between root surface caries of teeth and Actinomyces has been described.
Other sites colonized are the female genital tractand the tonsillar cryptsA number of Actinomyces species are isolated from the oral cavity. These include
Actinomyces israelii,Actinomyces gerencseriae,
Actinomyces odontolyticus,
Actinomyces Viscosus
Actinomyces Meyeri
A close relationship between Actinomyces odontolyticus and the earliest stages of enamel demineralization, and the progression of small caries lesions have been reported. The most important human pathogen is A. israelii.
Actinomyces israelii
Habitat and transmissionThis organism is a commensal of the mouth and possibly of the female genital tract.It is a major agent of human actinomycosis.
Characteristics
Gram-positive flamentous branching rods. Non-motile, non-sporing and non-acid-fast. Clumps of the organisms can be seen as yellowish ‘sulphur granules’ in pus discharging from sinus tracts, or the granules can be squeezed out of the lesions.(Strains belonging to A. israelii serotype II are now in a separate species, A. gerencseriae, a commonbut minor component of healthy gingival flora.)
• G/S :Variable cellular morphology, ranging from diphtheroidal to coccoid filaments มักพบ sulfur granule จากการย้อม gram ได้ และย้อมไม่ติด mAFB
Culture and identifcatio
Grows slowly under anaerobic conditions, on blood or serum glucose agar at 37°C. After about a week, it appears as small, creamy-white, adherent colonies on blood agar.‘
• The colonies resemble breadcrumbs or the surface of ‘molar’ teeth Because of the exacting growth requirements and the relatively slow growth, isolating this organism from clinical specimens is diffcult, particularly because the other, faster-growing bacteria in pus specimens tend to obscure the slow-growing actinomycetes.
• Actinomycosis
Sulphur granules’in lesions are a clue to their presence. When possible, these granules should be crushed, Gram-stained and observed for Gram-positive, branching flaments, and also cultured in preference to pus.
• G/S :sulfur granule
• Sulfur granulesACTINOMYCOSIS
Not highly virulent (Opportunist)Component of Oral Flora
Periodontal pockets
Dental plaque
Tonsilar crypts
Take advantage of injury to penetrate mucosal barriers
Coincident infection
Trauma
Surgery
pathophysiology
In general, Actinomyces species, being members of the normal flora, are agents of low pathogenicity and require disruption of the mucosal barrier to cause disease. Oral and cervicofacial diseases are commonly associated with dental procedures, trauma, oral surgery, or dental sepsis. Pulmonary infections usually arise after aspiration of oropharyngeal or GI secretions. GI infection frequently follows loss of mucosal integrity, such as with surgery, appendicitis, diverticulitis, trauma, or foreign bodies.Dr.T.V.Rao MD
13
Pathogenicity
Most (70–80%) actinomycotic infections are chronic, granulomatous, endogenous infections of the orofacial region.Typically, the lesions present as a chronic abscess,commonly at the angle of the lower jaw, with multiple external sinuses. There is usually a history of trauma such as a tooth extraction or a blow to the jaw.
Although most infections are monomicrobial in nature (i.e.with Actinomyces alone causing the disease), a signifcant proportion of infections could be polymicrobial, with other bacteria such as Aggregatibacter actinomycetemcomitans, Haemophilus spp. and anaerobes acting as co-infecting agents
People at risk with actinomycosis
Having a dental disease or recent dental surgery (for jaw abscess)Aspiration (liquids or solids are sucked into lungs) (for lung abscess)
Having bowel surgery (for abdominal abscess)
Swallowing fragments of chicken or other bones (for abdominal abscess)
For women: having an intrauterine contraceptive device (IUD) in place for many years (for abscess affecting the reproductive organs)
Dr.T.V.Rao MD
16
Infection Cervicofacial region
Dr.T.V.Rao MD
17Intestinal actinomycosis
Dr.T.V.Rao MD18
Abdominal actinomycosis
Dr.T.V.Rao MD19
Diagnosis:
.
Gram stain.
Culture. (poor growth in culture only in less than 50% of cases.) Sulphur granules (yellowish myecelial masses)
Specimens – open biopsy, aspiration material
The discharge should mix with sterile saline in a universal bottle and allow to stand, particles will separate out.
Place between 2 slides
Crush and gram stain
Observe for Gram positive branching filaments
Dr.T.V.Rao MD
20Examination of discharges will help in diagnosis
Examination of drained fluid under a microscope shows "sulphur granules" in the fluid. They are yellowish granules made of clumped organismsDr.T.V.Rao MD
21Treatment of actinomycosis
Treatment classically begins with IV penicillin for 2–6 weeks, followed by oral therapy with penicillin or amoxicillin for 6–12 months. For penicillin allergic patients, tetracycline, erythromycin, minocycline and clindamycin have been administered.
amoxicillin are now popular. Recalcitrant lesions respond
well to tetracycline because of its good bone penetration.
Surgical intervention may be necessary in chronic jaw
lesions.
Prevention of these infections is diffcult because of their
endogenous nature
22
Clostridia
Clostridia comprise many species of Gram-positive, anaerobic spore-forming bacilli (but spores are not found in infected tissues); a few are aerotolerant. They are an important group of pathogens widely distributed in soil and in the gut of humans and animals.There are four medically important species (Clostridium tetani, Clostridium botulinum, Clostridium welchii and Clostridium diffcile) that cause signifcant morbidity and mortality.
Clostridium spp.
HabitatSoil, water, decaying animal and plant matter, and human and animal intestines .Characteristics
Gram-positive rods, but older cultures may stain irregularly.characteristic endospores, which create a bulge in the bacterial body, for instance, the drum stick shaped C. tetani (this shape is useful in laboratory identifcation of the organisms).
Some species are motile with peritrichous flagella (e.g. C. tetani), while others (e.g. C. welchii) have a capsule
Culture and identifcation
Grow anaerobically on blood agar or Robertson’s cookedmeat medium (liquid culture).Although C. tetani and Clostridium novyi are strict anaerobes, Clostridium histolyticum and C. welchii can grow in the presence of limited amounts of oxygen (aerotolerant).
The saccharolytic, proteolytic and toxigenic potentials of the organisms are useful in identifcation.
Clostridium welchii
Habitat and transmissionSpores are found in the soil, and vegetative cells are normalflora of the colon and vagina. This bacterium causes twodiscrete diseases, due to either exogenous or endogenousinfection:• gas gangrene (myonecrosis) resulting from infection ofdirty ischaemic wounds (e.g. war injuries)• food poisoning due to ingestion of food contaminatedwith enterotoxin-producing strains.
Clostridium welchii
CharacteristicsA short, fat bacillus. Spores are not usually found as they areformed under nutritionally defcient conditions. More tolerant of oxygen than other clostridia.Clostridium welchii
ToxinsA variety of toxins (at least 12), including collagenase, proteinase and hyaluronidase, are formed, the most notable ofwhich is the α-toxin, which lyses the phospholipids ofeukaryotic cell membranes (i.e. a phospholipase). C. welchiiis divided into fve types (A–E) on the basis of toxins formed;type A is the human pathogen.Clostridium welchii
Culture and identifcationGrows well on blood agar under anaerobic conditions, producing β-haemolytic colonies; some are non-haemolytic.The saccharolytic characteristic is used for identifcation purposes as it ferments litmus milk, producing acids and gasesresponsible for the so-called ‘stormy-clot’ reaction.Clostridium welchii
PathogenicityCauses gas gangrene and food poisoning.Gas gangrene (myonecrosis)Wounds associated with traumatized tissue (especially muscle) may become infected with C. welchii and other clostridia, with severe, life-threatening spreading infection. Activity of the bacillus in injured tissue results in toxin and enzyme production, allowing the organism to establish and multiply in the wound. Characteristic signs and symptoms include pain, oedema and crepitation produced by gas in tissues
Clostridium welchii
Food poisoningSome strains of C. welchii produce an enterotoxin thatinduces food poisoning. This is due to the ingestion of largenumbers of vegetative cells from contaminated food, whichthen sporulate in the gut and release enterotoxin. The diseaseis characterized by watery diarrhoea with little vomitingClostridium welchii
Treatment and preventionGas gangreneRapid intervention with:1. extensive debridement of the wound2. antibiotics (penicillin or metronidazole)3. anti-α-toxin administration.Clostridium tetani
Habitat and transmissionC. tetani is present in the intestinal tract of herbivores, andspores are widespread in soil. Germination of spores is promoted by poor blood supply and necrotic tissue and debrisin wounds.Clostridium tetani
CharacteristicsLong, thin bacilli with terminal spores giving the characteristic ‘drumstick’ appearance. Produces an extremely potentneurotoxin, tetanospasmin, by vegetative cells at the woundsite. Another less powerful toxin, tetanolysin, is haemolyticin nature protected with antitoxin and the other is unprotected; thelatter dies with typical tetanic spasms.Clostridium tetani
PathogenicityThe agent of tetanus (lockjaw), which is a typical toxinmediated disease. The powerful, heat-labile neurotoxin(tetanospasmin) is produced at the wound site and releasedduring cell lysis, It is retrogradely carried via theperipheral nerves (intra-axonally) to the central nervoussystem where it blocks inhibitory mediators at spinal synapses. This causes sustained muscle spasm and the characteristic signs of spasm of jaw muscles (lockjaw, trismus) andfacial muscles (risus sardonicus), and arching of the body(opisthotonos). Toxin genes are plasmid-coded. C. tetanialso produces an oxygen-labile haemolysin (tetanolysin);the clinical signifcance of this enzyme is not clearClostridium tetani
Treatment and preventionAntitoxin (hyperimmune human α-globulin) administeredwith or without toxoid, depending on the immunizationhistory of the patient. Prevention is by tetanus toxoidcomponent of the diphtheria–tetanus–pertussis (DTP)vaccine) with boosters every 10 years,Proper wound debridement and administration of penicillin(to inhibit clostridial growth and secondary infection) are other important management measures.Clostridium diffcile
Found in the faeces of 3–6% adults and almost all healthyinfants, C. diffcile is the agent of antibiotic-associatedcolitis, which may lead to sometimes lethal pseudomembranous colitis. It multiplies in the gut under the selectivepressure of antibiotics. Although clindamycin was earliersingled out as the main cause of colitis, it is now known thatcommon drugs such as ampicillin may occasionally precipitate the disease. Treatment is to withhold the offending antibiotic and administer oral vancomycin or metronidazole.As much as 25% of the common antibiotic-associateddiarrhoea is considered to be due to C. diffcile.